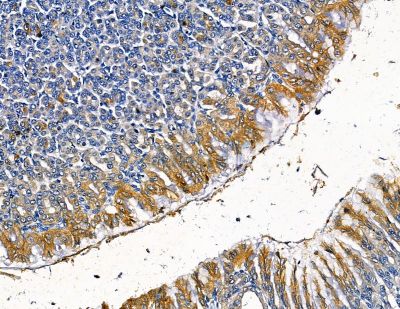
TFB2M Antibody - DF13810 at 1/100 staining rat stomach tissue by IHC-P.

TFB2M Antibody - #DF13810
Related Downloads
Protocols
Product Info
*The optimal dilutions should be determined by the end user. For optimal experimental results, antibody reuse is not recommended.
*Tips:
WB: For western blot detection of denatured protein samples. IHC: For immunohistochemical detection of paraffin sections (IHC-p) or frozen sections (IHC-f) of tissue samples. IF/ICC: For immunofluorescence detection of cell samples. ELISA(peptide): For ELISA detection of antigenic peptide.
Fold/Unfold
N''-adenosyl(rRNA) dimethyltransferase 2; S adenosylmethionine 6 N', N' adenosyl(rRNA) dimethyltransferase 2; Dimethyladenosine transferase 2; dimethyladenosine transferase 2 mitochondrial; FLJ22661; FLJ23182; h mtTFB; h mtTFB2; h-mtTFB; h-mtTFB2; HCV NS5A transactivated protein 5; HCV NS5A-transactivated protein 5; hepatitis C virus NS5A transactivated protein 5; Hepatitis C virus NS5A-transactivated protein 5; Hkp1; hTFB2M; Mitochondrial 12S rRNA dimethylase 2; mitochondrial; Mitochondrial dimethyladenosine transferase 2; Mitochondrial transcription factor B2; mtTFB; mtTFB2; NS5ATP5; S-adenosylmethionine-6-N''; TFB2M; TFB2M_HUMAN; Transcription Factor B2; Transcription factor B2 mitochondrial;
Immunogens
A synthesized peptide derived from Human TFB2M.
- Q9H5Q4 TFB2M_HUMAN:
- Protein BLAST With
- NCBI/
- ExPASy/
- Uniprot
MWIPVVGLPRRLRLSALAGAGRFCILGSEAATRKHLPARNHCGLSDSSPQLWPEPDFRNPPRKASKASLDFKRYVTDRRLAETLAQIYLGKPSRPPHLLLECNPGPGILTQALLEAGAKVVALESDKTFIPHLESLGKNLDGKLRVIHCDFFKLDPRSGGVIKPPAMSSRGLFKNLGIEAVPWTADIPLKVVGMFPSRGEKRALWKLAYDLYSCTSIYKFGRIEVNMFIGEKEFQKLMADPGNPDLYHVLSVIWQLACEIKVLHMEPWSSFDIYTRKGPLENPKRRELLDQLQQKLYLIQMIPRQNLFTKNLTPMNYNIFFHLLKHCFGRRSATVIDHLRSLTPLDARDILMQIGKQEDEKVVNMHPQDFKTLFETIERSKDCAYKWLYDETLEDR
Research Backgrounds
S-adenosyl-L-methionine-dependent rRNA methyltransferase which may methylate two specific adjacent adenosines in the loop of a conserved hairpin near the 3'-end of 12S mitochondrial rRNA (Probable). Component of the mitochondrial transcription initiation complex, composed at least of TFB2M, TFAM and POLRMT that is required for basal transcription of mitochondrial DNA. In this complex, TFAM recruits POLRMT to a specific promoter whereas TFB2M induces structural changes in POLRMT to enable promoter opening and trapping of the DNA non-template strand. Stimulates transcription independently of the methyltransferase activity.
Mitochondrion.
Ubiquitously expressed.
Belongs to the class I-like SAM-binding methyltransferase superfamily. rRNA adenine N(6)-methyltransferase family. KsgA subfamily.
Restrictive clause
Affinity Biosciences tests all products strictly. Citations are provided as a resource for additional applications that have not been validated by Affinity Biosciences. Please choose the appropriate format for each application and consult Materials and Methods sections for additional details about the use of any product in these publications.
For Research Use Only.
Not for use in diagnostic or therapeutic procedures. Not for resale. Not for distribution without written consent. Affinity Biosciences will not be held responsible for patent infringement or other violations that may occur with the use of our products. Affinity Biosciences, Affinity Biosciences Logo and all other trademarks are the property of Affinity Biosciences LTD.